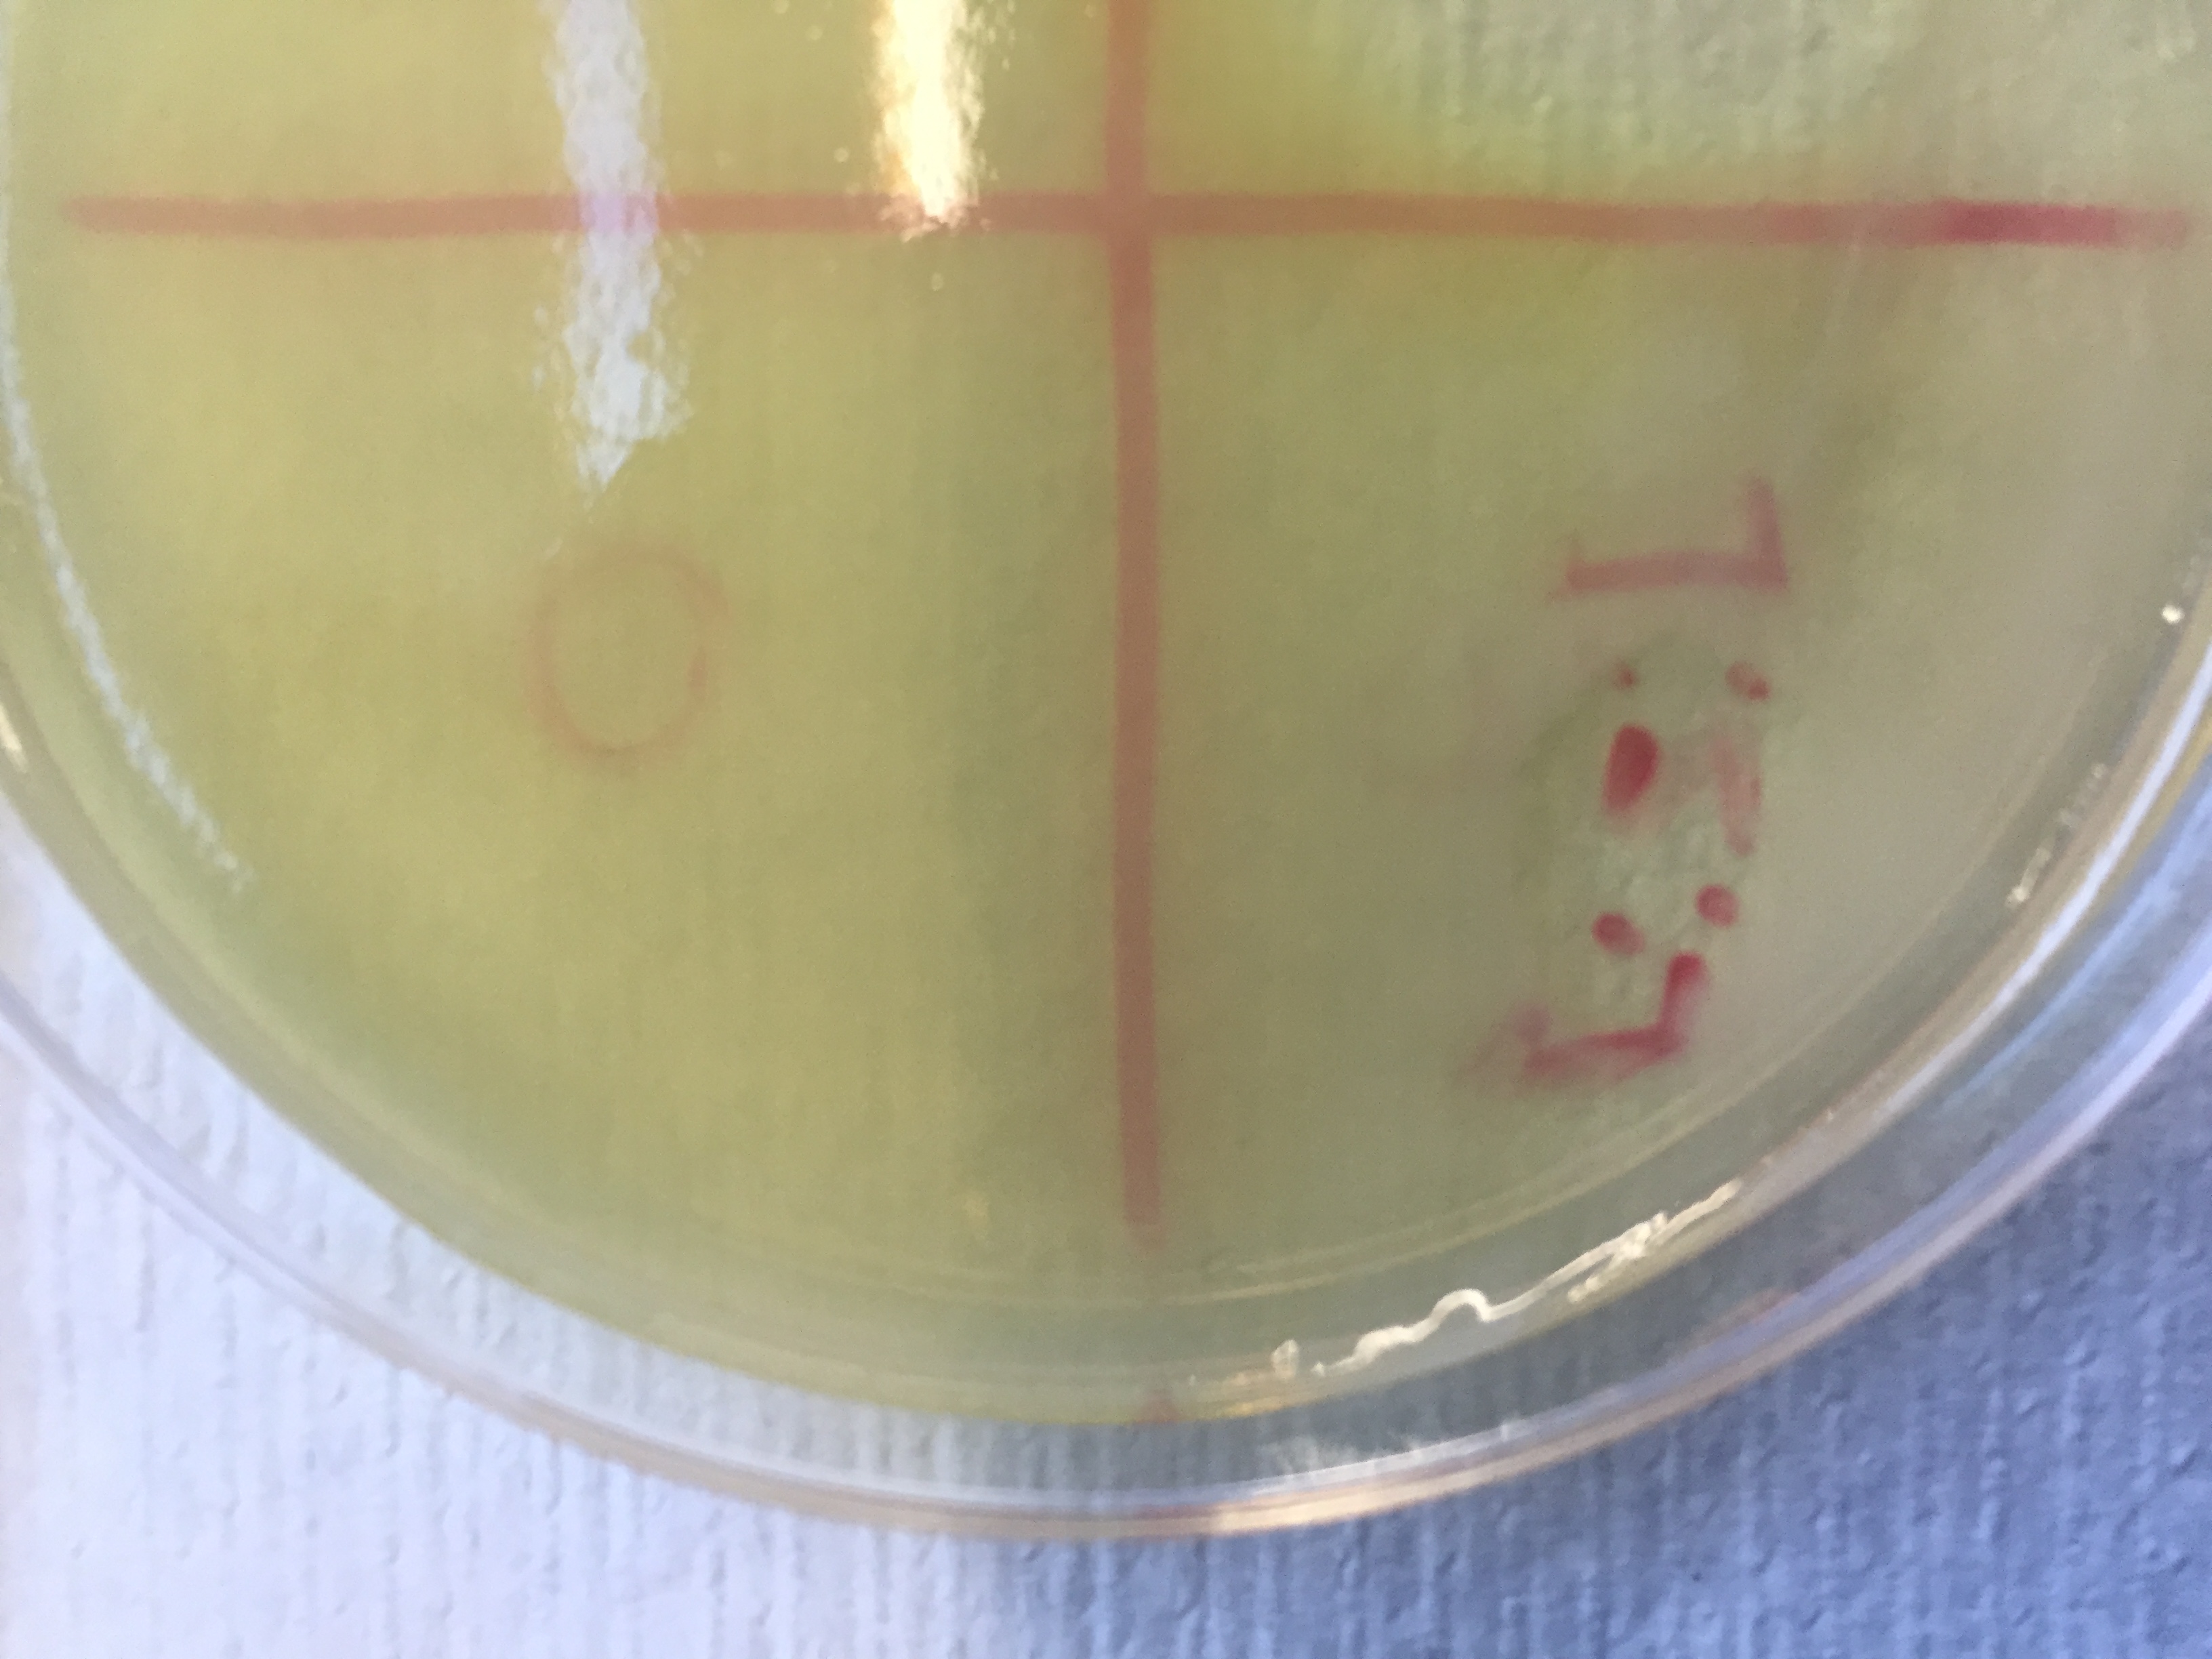
IMG_1413.jpg
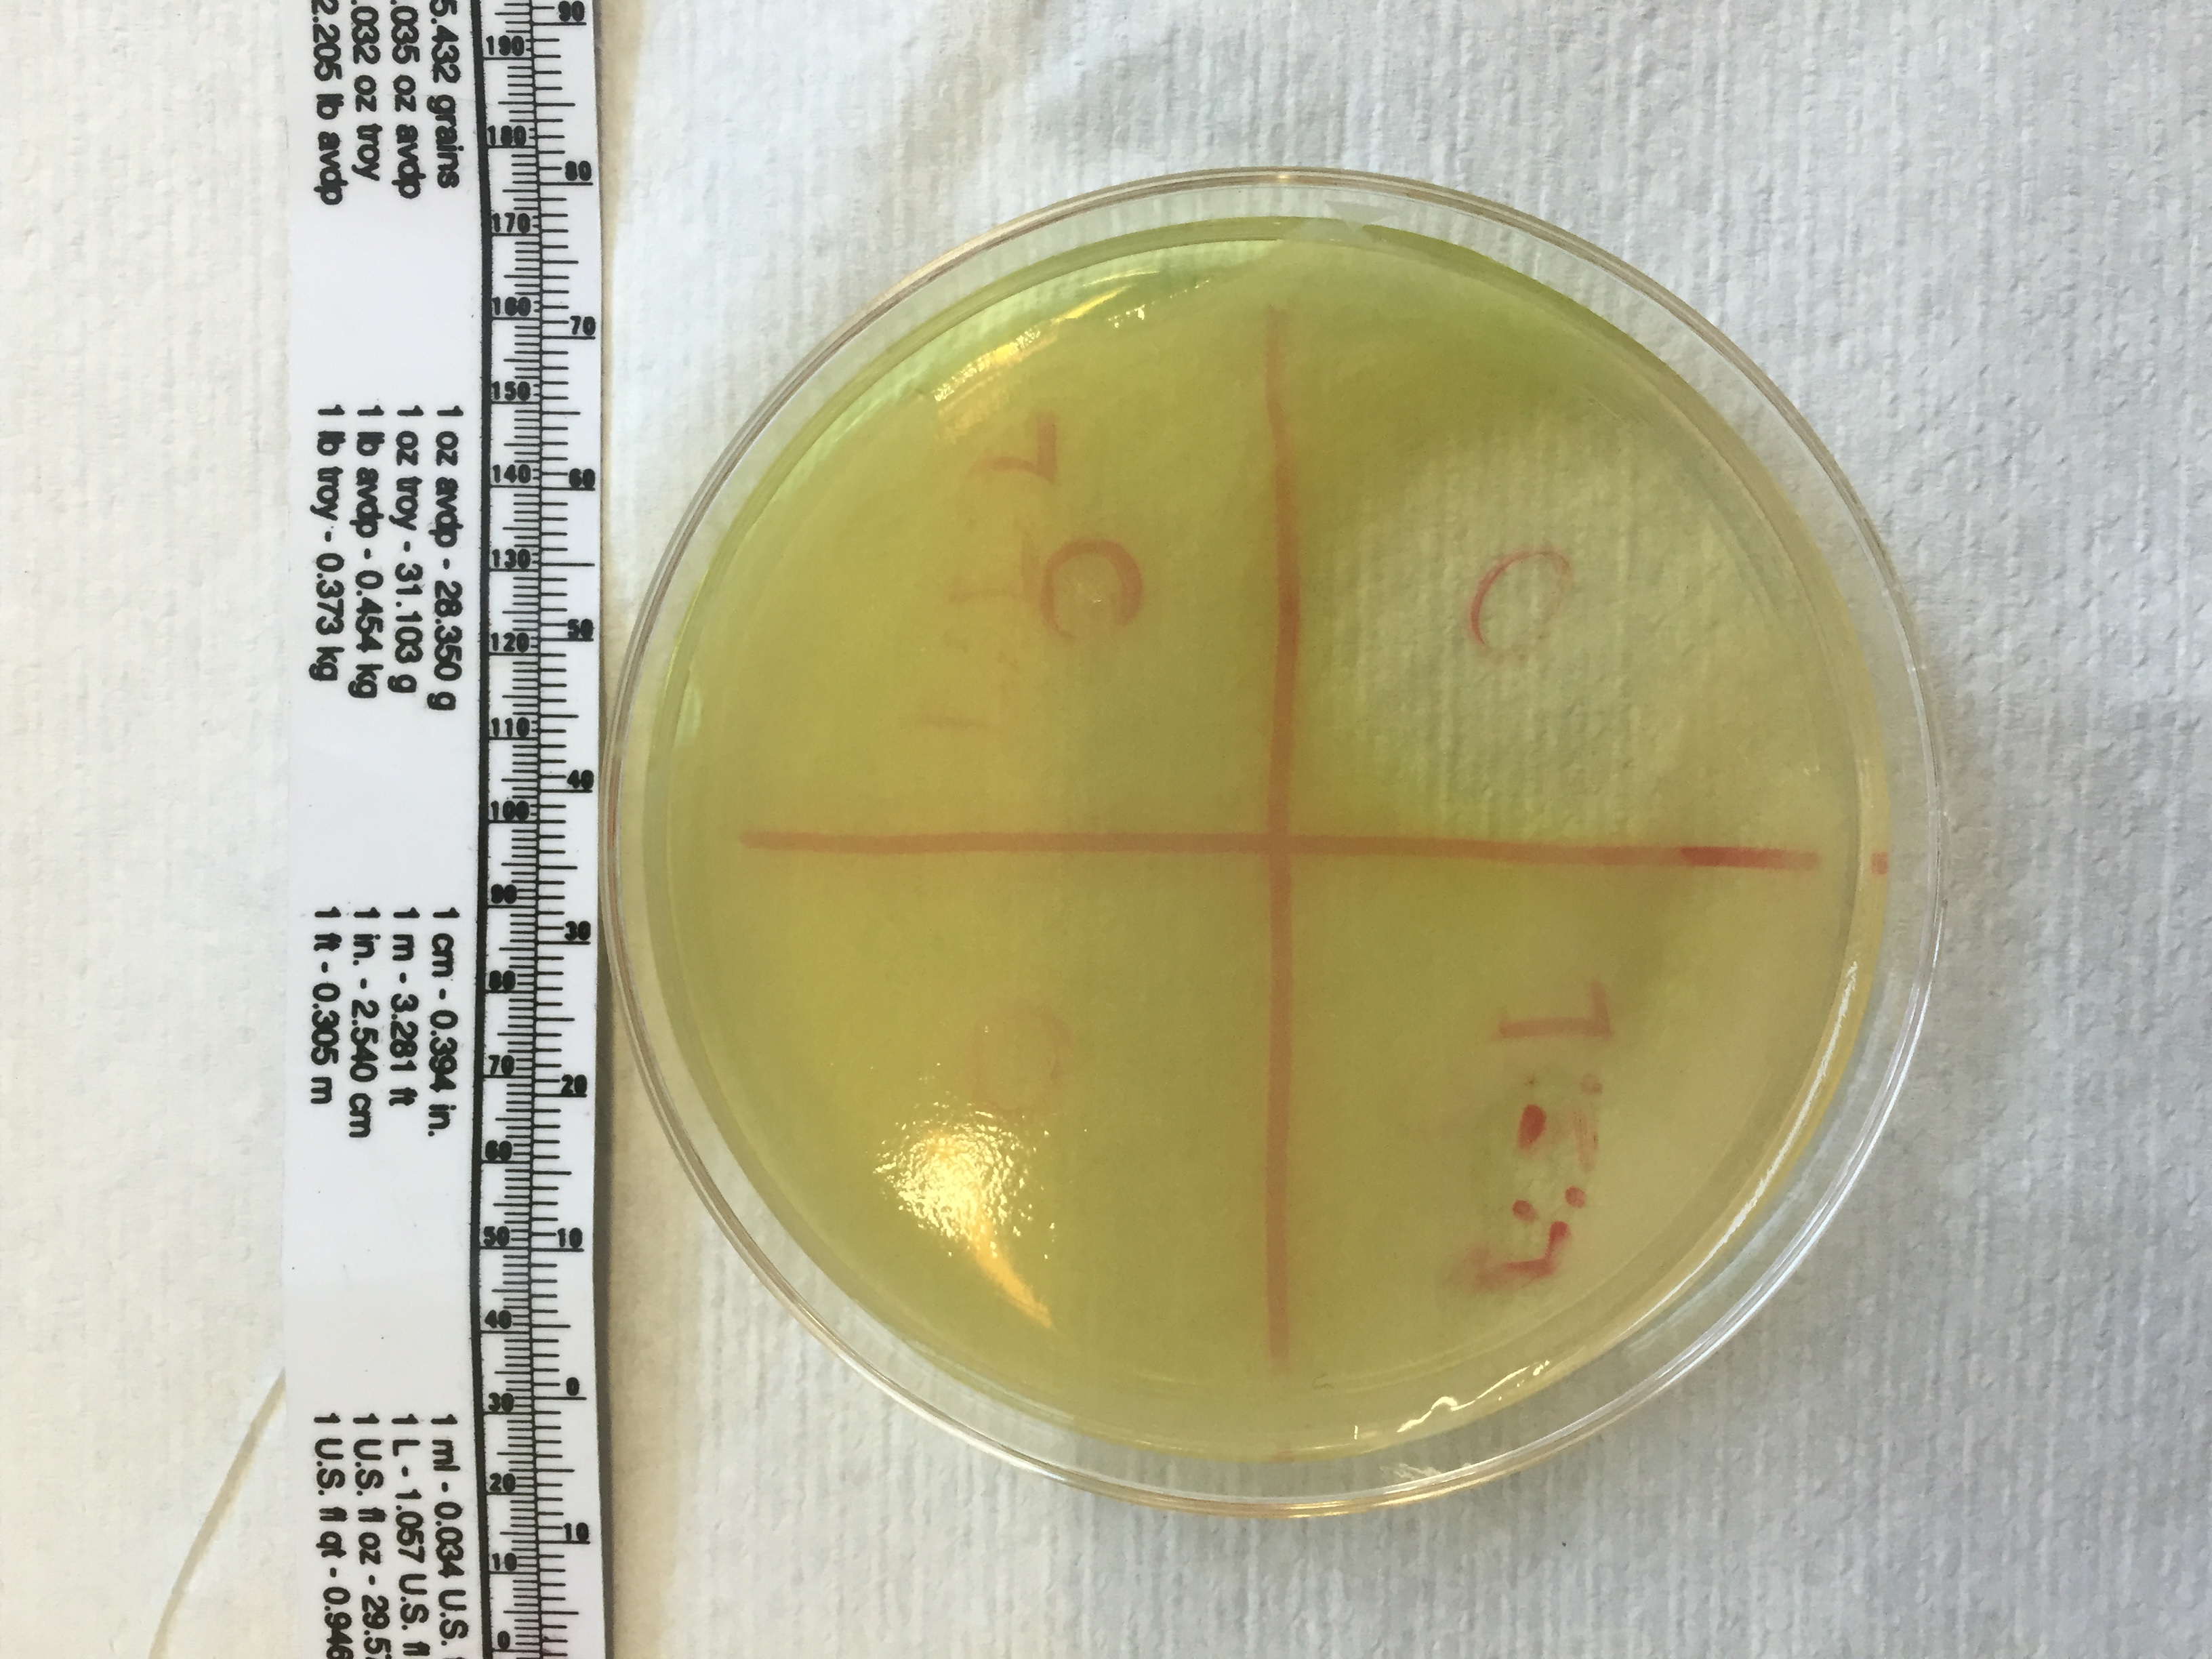
IMG_1412.jpg
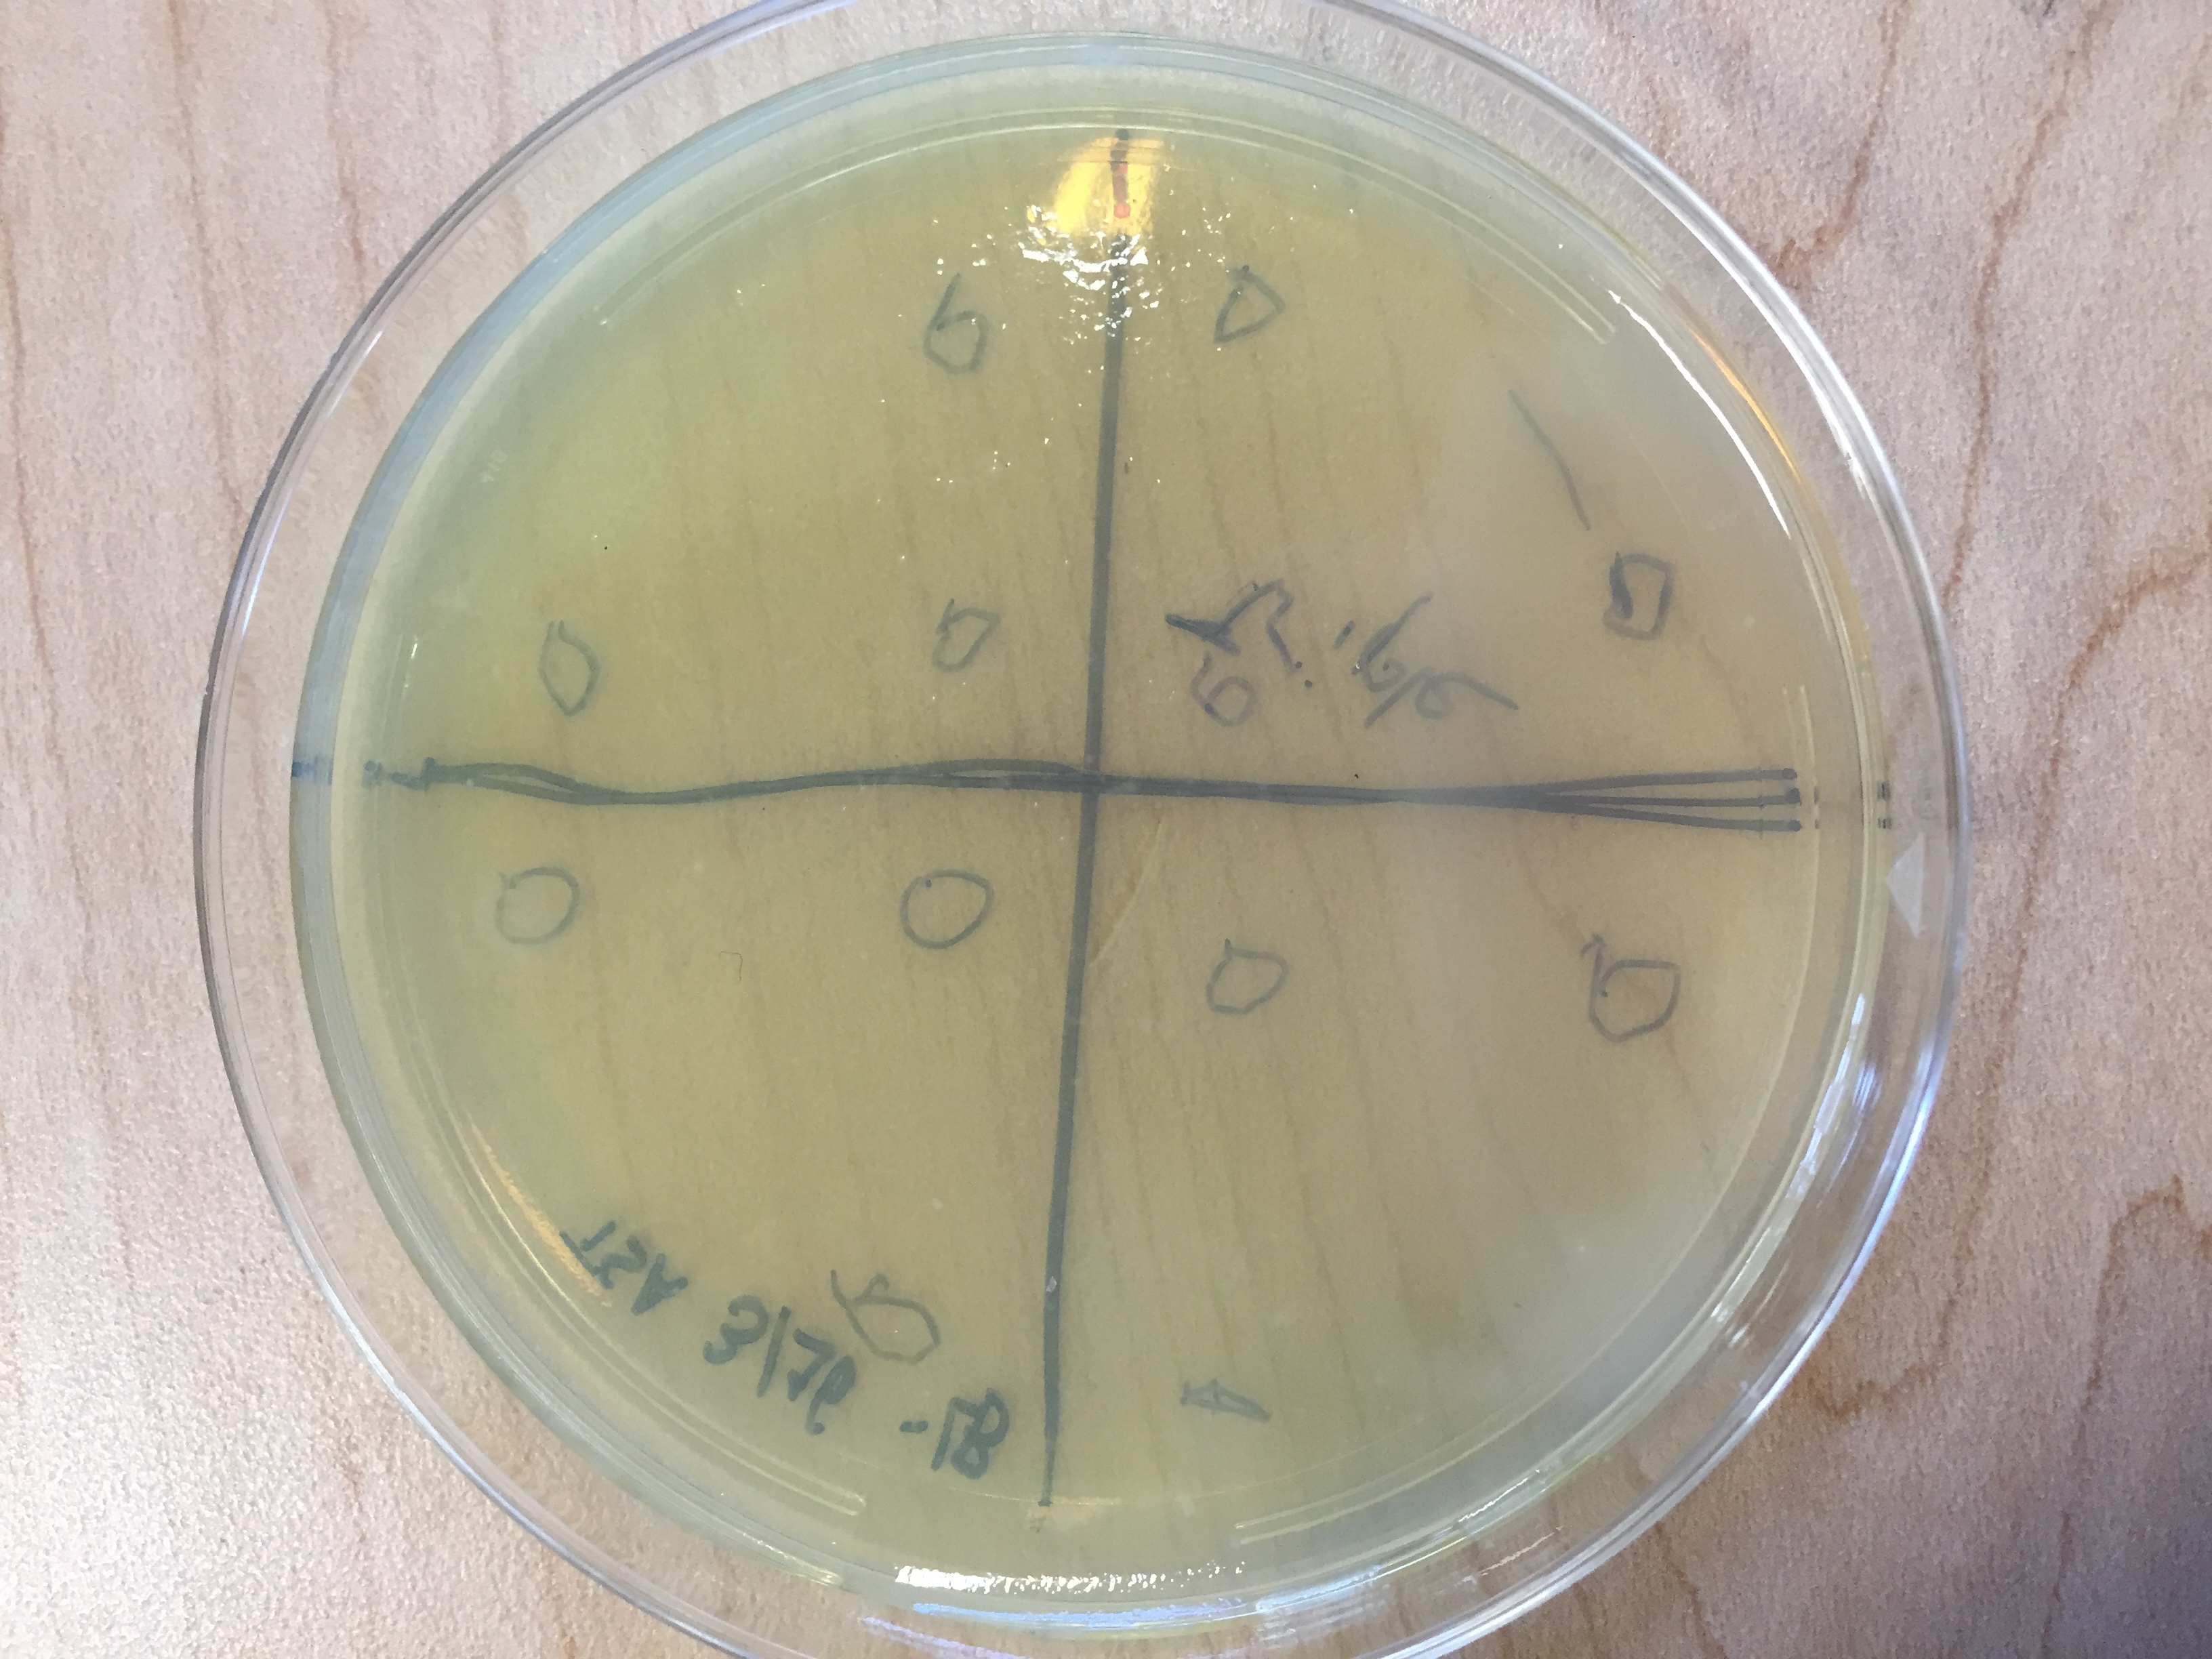
IMG_1301.jpg
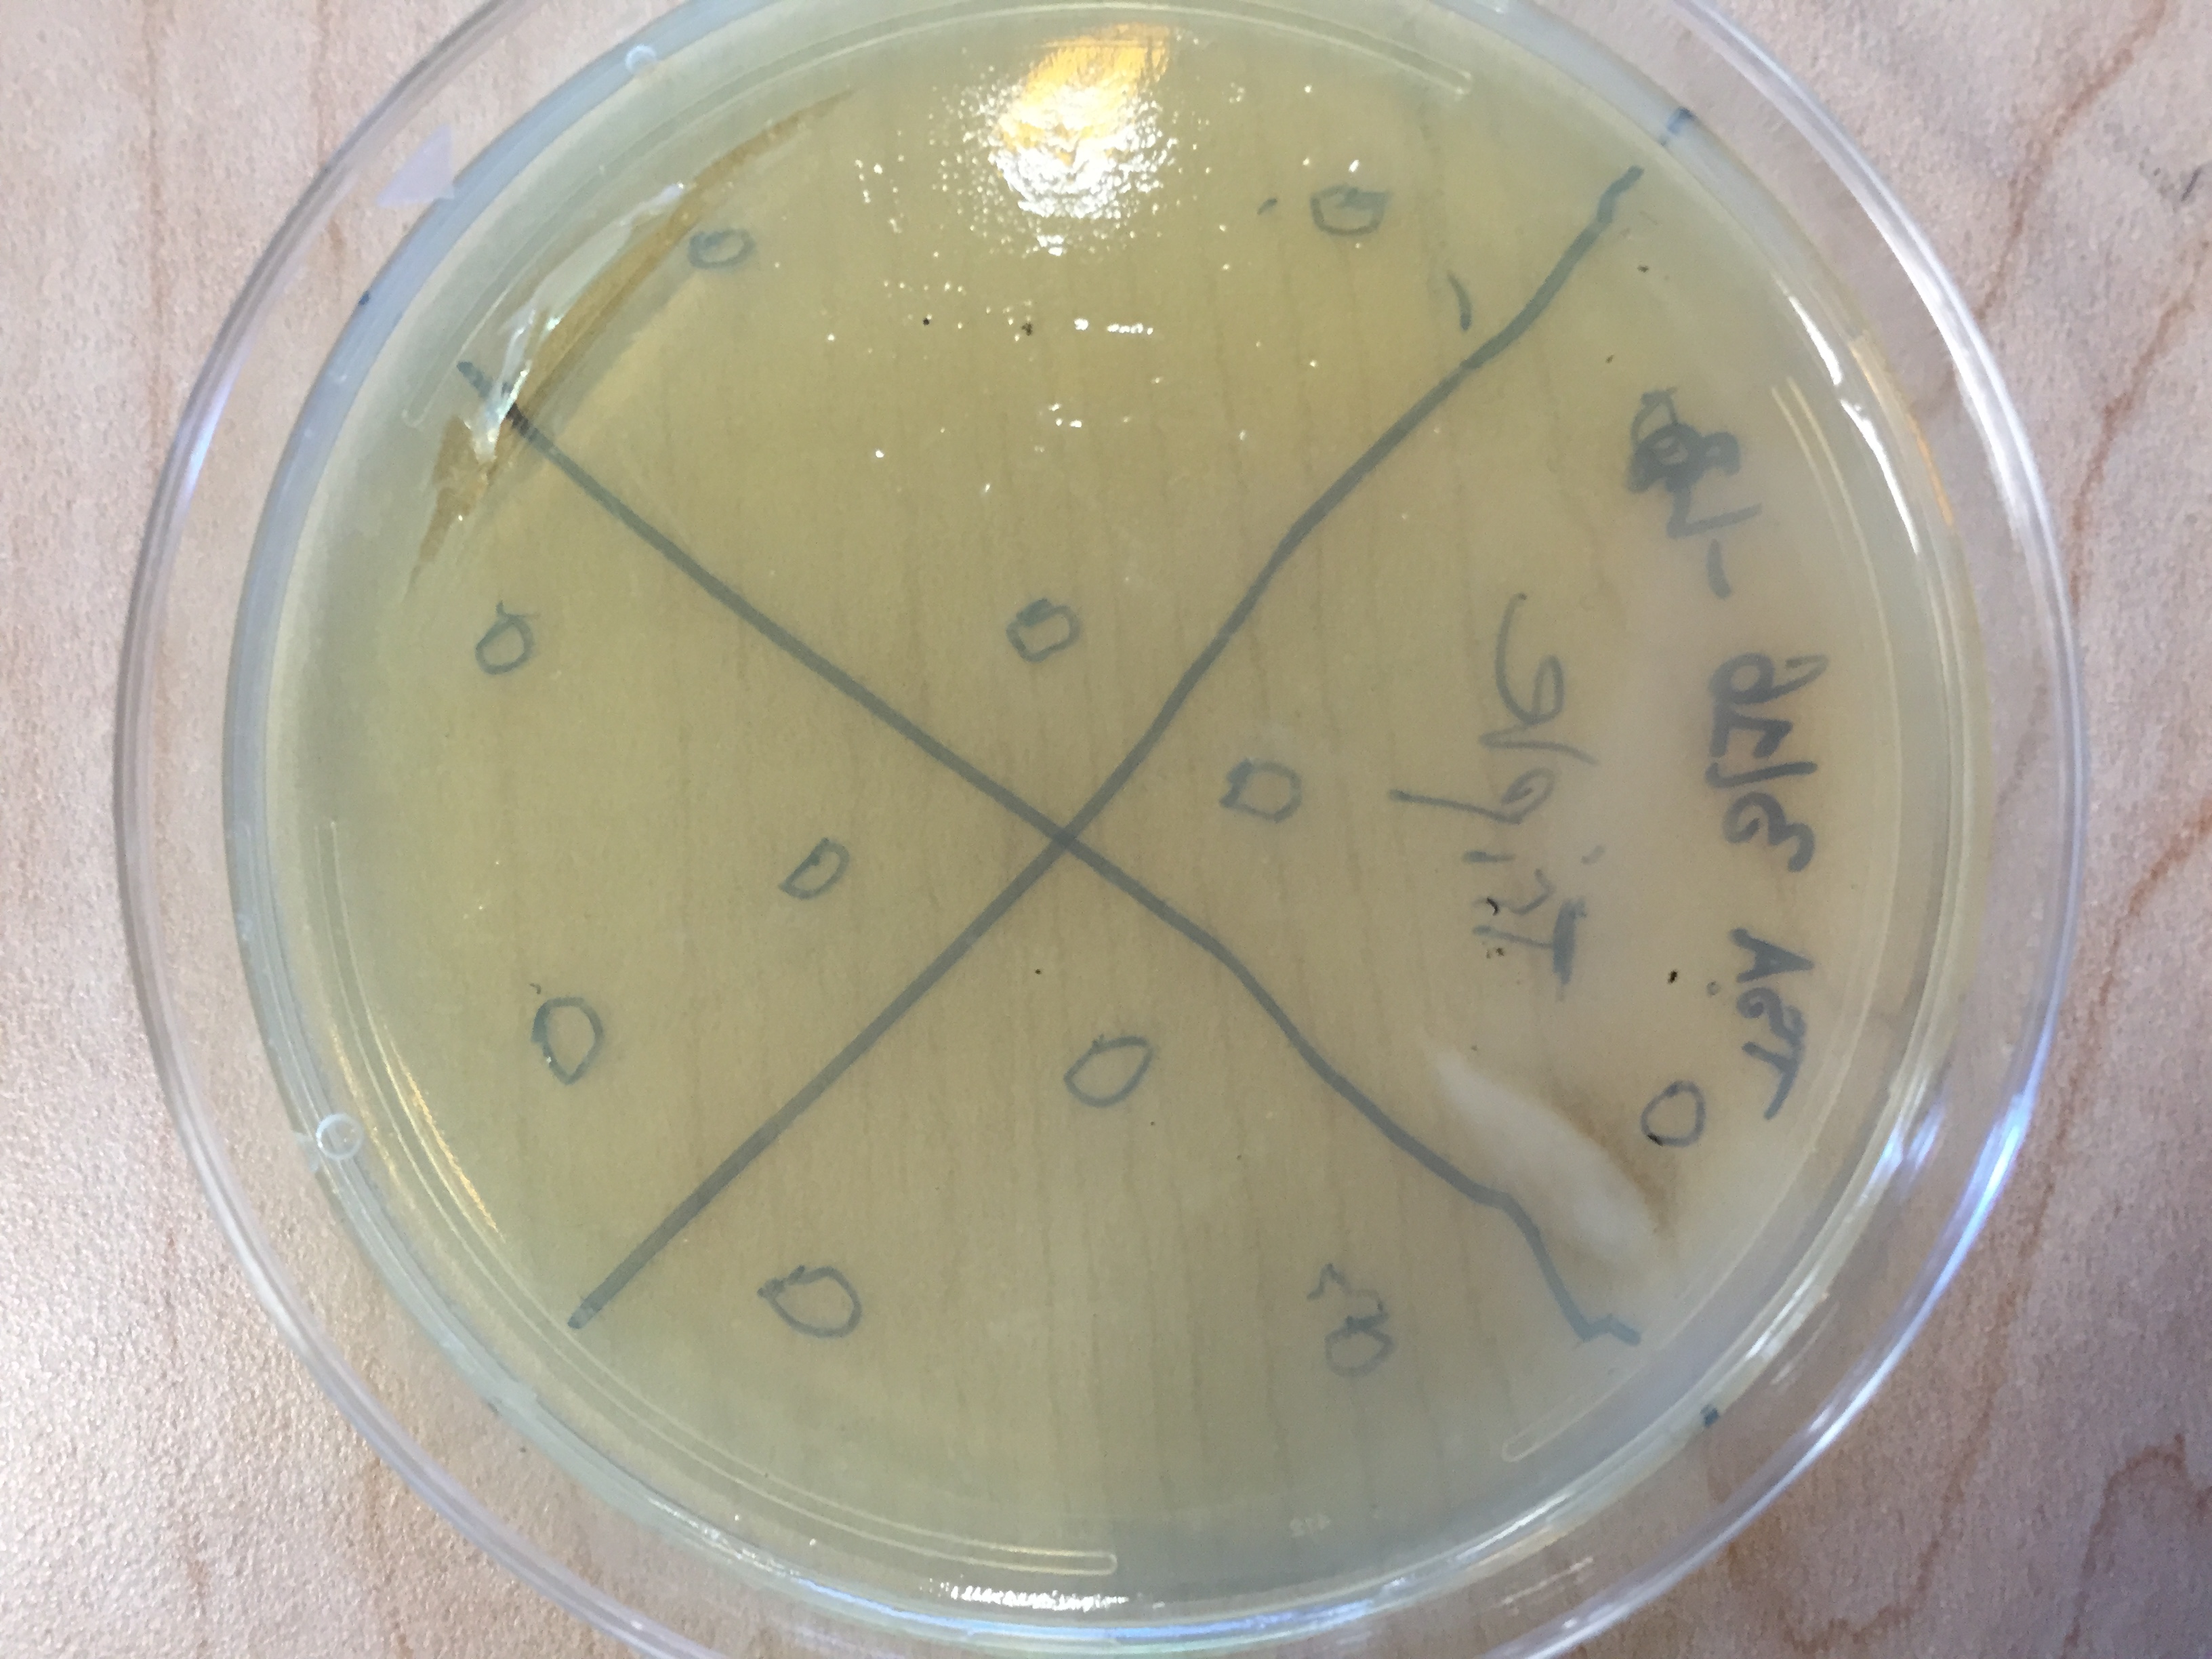
IMG_1302.jpg

Activity

Microorganisms

Unknown

Fungi & Lichen

Plants

Insects

Animals

Non Living

Information

Workshops

Lesson Plans
Mediashowing 12 of 13

Photo posted on Dec 23, 2025
image

Photo posted on Dec 23, 2025
image

Photo posted on Dec 23, 2025
image

Photo posted on Dec 23, 2025
image
Photo posted on Dec 23, 2025
image
Photo posted on Dec 23, 2025
image

Photo posted on Dec 23, 2025
image

Photo posted on Dec 23, 2025
image

Photo posted on Dec 23, 2025
image

Photo posted on Dec 23, 2025
image
Photo posted on Dec 23, 2025
image
Photo posted on Dec 23, 2025
image
More Posts from Leonardo Biralshowing 3 of 3
Similar Foldscopers
I am a Boy studing in 7th class in India,Maharashtra,Amravati
I will show you spme interesting things which i,ll observe by my foldscope
No post images available.
No biography available.
No post images available.
No biography available.
No post images available.
No biography available.
No post images available.
Pollen Project
DC MICRONAUTS
No post images available.
No biography available.
No post images available.
No biography available.
No post images available.
No biography available.
No post images available.
No biography available.
No post images available.
No biography available.
No post images available.

 Joined Jan 11, 2016
Joined Jan 11, 2016
 0 Applause
0 Applause 0 Comments
0 Comments









